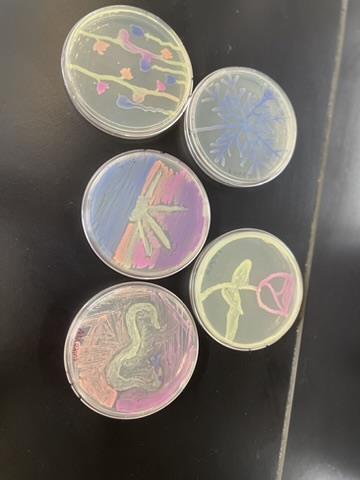

Select a School...
Select a School
- Adams Elementary School
- AESM Middle School at LOuverture
- Alternative Education
- Ames Visual & Performing Arts Elementary
- Ashland Elementary School
- Back to School 2024-25
- Betty Wheeler Classical Junior Academy
- Bryan Hill Elementary School
- Buder Elementary School
- Busch Middle School of Character
- Carnahan STEAM
- Carr Lane VPA Middle School
- Central VPA High School
- Citywide Planning Committee
- Clyde C. Miller Career Academy High School
- Collegiate School of Medicine & Bioscience
- Columbia Elementary School
- Compton-Drew ILC Middle School
- Dewey IS Elementary School
- ETS at Madison
- Educators for Gun Safety
- Success Academy @ Sumner High School
- Froebel Literacy Academy Elementary School
- Gateway Michael Elementary School
- Gateway MST Elementary School
- Gateway MST Middle School
- Gateway STEM High School
- George Washington Carver Elementary Academy
- Hamilton Elementary School
- Herzog Elementary School
- Hickey Elementary School
- Hodgen Tech Academy
- Humboldt Academy of Higher Learning Elementary School
- Jefferson Elementary School
- Lexington Elementary School
- Literacy for the Lou
- Long International Middle School
- Lyon Academy at Blow PK-8
- Mallinckrodt Academy of Gifted Instruction
- Mann Elementary School
- Mason School of Academic & Cultural Literacy Elementary School
- McKinley CLA High School
- McKinley Classical Leadership Academy
- Meramec Elementary School
- Metro Academic and Classical High School
- Monroe Elementary School
- Mullanphy-Botanical Garden Elementary School
- Nahed Chapman New American Academy
- Nance Elementary School
- Nottingham CAJT High School
- Oak Hill Elementary School
- Pamoja Preparatory Academy at Cole
- Patrick Henry Downtown Academy
- Peabody Elementary School
- Laclede Junior Career Academy
- Proposition S Updates
- Roosevelt High School
- Shaw Visual and Performing Arts Elementary School
- Shenandoah Elementary School
- Sigel Elementary School
- SLPS Building Revitalization Collaborative
- Soldan International Studies High School
- Stix ECC Elementary School
- Sumner High School
- Work for Saint Louis Public Schools
- Vashon High School
- Walbridge STEAM Academy
- Washington Montessori Elementary School
- Wilkinson Early Childhood Center @ Roe Elementary School
- Woerner Elementary School
- Woodward Career Academy
- Yeatman-Liddell Preparatory Middle School